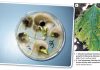
Alternaria leaf blight and seed infection: A common disease causing major damage

April 2017

Beste Grootneef
Soos Buurman verlede week vir Mevrou Dominee in die bad sê: Die wêreld is boos. Kyk nou net hoe die nuwe baas van PRASA verduidelik oor die verhoging van 350% wat hy aan homself toegeken het. Dis nou dieselfde besigheid wat laasjaar Spaanse treine bestel het wat nie pas nie.
Buurman sê die hogeres lyk altyd so hartseer as hul streke op die lappe kom. Nie omdat hul jammer is oor wat hul gedoen het nie, maar dat hul uitgevang is. Want dan moet hul ‘n ambassadeur of ‘n LP word vir ‘n kwart van die salaris wat hul voorheen vir hulself gereël het. Maar dis nou wat gebeur as jy van ‘n grasbesem ‘n vacuum cleaner wil maak.
Ou Neef, die weiveld in die Vrystaat is mooier as ooit. Vanjaar gee dit so ‘n kykie van hoe die paradys voor die sondeval moes gelyk het. Wanneer jy met ‘n bakkie deur die veld ry, voel dit kompleet asof jy met ‘n boot deur die golwe van wuiwende rooigras gly. Vroegoggend al gaan lê die beeste en herkou, blink gevreet in die lang gras. Hoe het die wêreld nie in ‘n paar maande verander nie – laasjaar die tyd was die ellende hoog, met noodvoer wat vir die winter ingery moes word. Net genade ou Neef, net genade.
Die nat weer het natuurlik ook sy bondel sports gehad; met party manne wat met trekkers deur die vleie en spruite moes dorp toe. Geen bakkie kon deur die hoogwater kom nie. Maar met die sak van die water terug tot in die natuurlike lope van vleie en spruite, wou algar gaan kyk tot waar die water op gestoot het. Die opdrifsels teen die drade en bome vertel mos ‘n eie storie van hoe breed en wyd ‘n spruit geloop het.
Dit was ‘n Maandagoggend dat ons verneem het van Buurman se groot sit. Die spruit se geel potklei was so glad soos seep en sy Ford het van die wal tot in die sloot gegly. Gelukkig was daar ‘n selfoonsein sodat hy hulp kon ontbied. ‘n Gewone bakkie sou dit nie maak nie, maar Buurman laat weet dat ons sy ou Land Rover moet stuur om hom uit te sleep. Só is ons terug tot by sy stoor om sy Landy aan die gang te kry. Dié kan enige pad ry.
Daar gekom, word die enjinkap behendig deur Amos oopgemaak en met ‘n plank gestut om nie toe te val nie. Die waterwerke kry so 2 liter water gesluk en toe word die filter se deksel afgeskroef vir ‘n doppie kwik start in elke keelgat af. Met die filter weer toe, draai Amos die sleutel in stille afwagting. Die starter gee egter net so klak-geluid, maar met geen belofte van ‘n vonk om lewe aan die ou kolos te gee nie.
En toe sak ek en Amos maar in skrumformasie teen die Engelse maaksel. Ek agter en Amos in flank posisie langs die Landy se deur. Op crouch and engage krap Amos die klip onder die voorwiel uit en toe stoot ons. Met ‘n geknars het die Landy se wiele stadig begin rol. Toe die afdraande en swaartekrag oorvat, kon Amos vinnig inspring, die eerste rat instamp en die koppelaar los. Met ‘n sidderende hoes is die kwik start tot in die Landy se binneste. En toe vat hy met ‘n bol rook en ‘n knal soos ‘n 303. Al die hoenders op hol en die stoorkat teen die balke uit. Amos ref toe daai Landy dat die hele ding staan en sidder en beef soos ‘n gelaaide flossie op Grootfontein se aanloopbaan.
“Sy’s nou reg,” het Amos tevrede laat weet en is toe met die proesende Landy die werf uit om vir Buurman uit die spruit te sleep.
Ek dink toe by myself, die Engelse het ons waarlik gestraf met die klomp Landy’s wat hul hier gelos het. Die voordeel van ‘n ou Landy is weliswaar dat jy nie met ‘n GPS hoef te sukkel nie. Jy ry sommer net op die oliestreep terug huis toe.
Ou Neef, groete op die Oosgrens! Maak solank daardie .30-06 skoon en soek die biltonghakies. Die winter is op ons.
Kleinneef
Lesers is welkom om ‘n e-pos aan Kleinneef te stuur by kleinneef@graingrowers.co.za.
Publication: April 2017
Section: Features